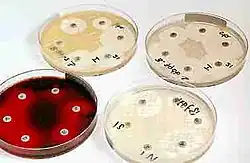

Antibiograma
Un antibiograma es una prueba microbiológica que se realiza para determinar la susceptibilidad (sensibilidad o resistencia) de una bacteria a un grupo de antibióticos. Las técnicas de antibiograma son las utilizadas en el laboratorio de microbiología para estudiar la actividad de los antimicrobianos frente a los microorganismos responsables de las infecciones.
Se considera como antimicrobiano cualquier sustancia con capacidad de matar o al menos de inhibir el crecimiento de los microorganismos y que sea susceptible de utilización como tratamiento en los pacientes. Pueden ser naturales, sintéticos o semisintéticos (modificación química de un compuesto natural). La historia moderna de los antibióticos comienza con el descubrimiento de sustancias presentes en unos microorganismos capaces de matar a otros microorganismos. La utilización de antibióticos supuso un avance enorme en la esperanza de vida de las personas que padecían procesos infecciosos, aunque desgraciadamente también supuso un aumento en los niveles de resistencia antibiótica.
El antibiograma tiene cuatro utilidades principales:
La utilidad básica del antibiograma es la instauración de un tratamiento antibiótico correcto al paciente. Es necesario conocer si el microorganismo responsable de la infección posee mecanismos que le confieran resistencia frente a algún antibiótico para no incluirlo como terapia.
En cuanto al tratamiento el antibiograma no solo es necesario en la instauración, también resulta útil en el seguimiento e incluso en la confirmación de tratamientos empíricos. En ocasiones la enfermedad infecciosa resulta grave y se comienza el tratamiento antes de conocer los datos de sensibilidad de la cepa. El antibiograma tiene que confirmar, o en su caso corregir el tratamiento.
Otra aplicación de las técnicas de estudio de resistencia es la epidemiología. Es necesario detectar el aumento de los niveles de resistencia en los aislamientos clínicos para tomar medidas correctoras.
Por otro lado, también puede tener utilidad diagnóstica porque el perfil de resistencia puede en algún caso orientar en la identificación bacteriana.
Existen multitud de antimicrobianos en el mercado y el número sigue creciendo porque el desarrollo de más mecanismos de resistencia por parte de los microorganismos se traduce en un esfuerzo mayor por fabricar más y mejores antibióticos. No es necesario contrastar la eficacia de todos los antibióticos para cada aislamiento bacteriano. Los criterios que se siguen para seleccionar que antimicrobianos se ensayan respondes a factores de diversa índole:
Factores microbiológicos: Tipo de agente infeccioso y mecanismos de resistencia descritos previamente en su especie.
Factores farmacológicos: Tipo de antimicrobiano y parámetros de absorción, distribución y eliminación.
Factores del paciente: Tipo de infección. Factores de riesgo y estado general de salud. Situación inmunológica e hipersensibilidad.
Experiencia anterior referente a los patrones de resistencia antibiótica más habituales para cada especie.
Enlaces externos
- Técnicas de Antibiograma (en inglés)